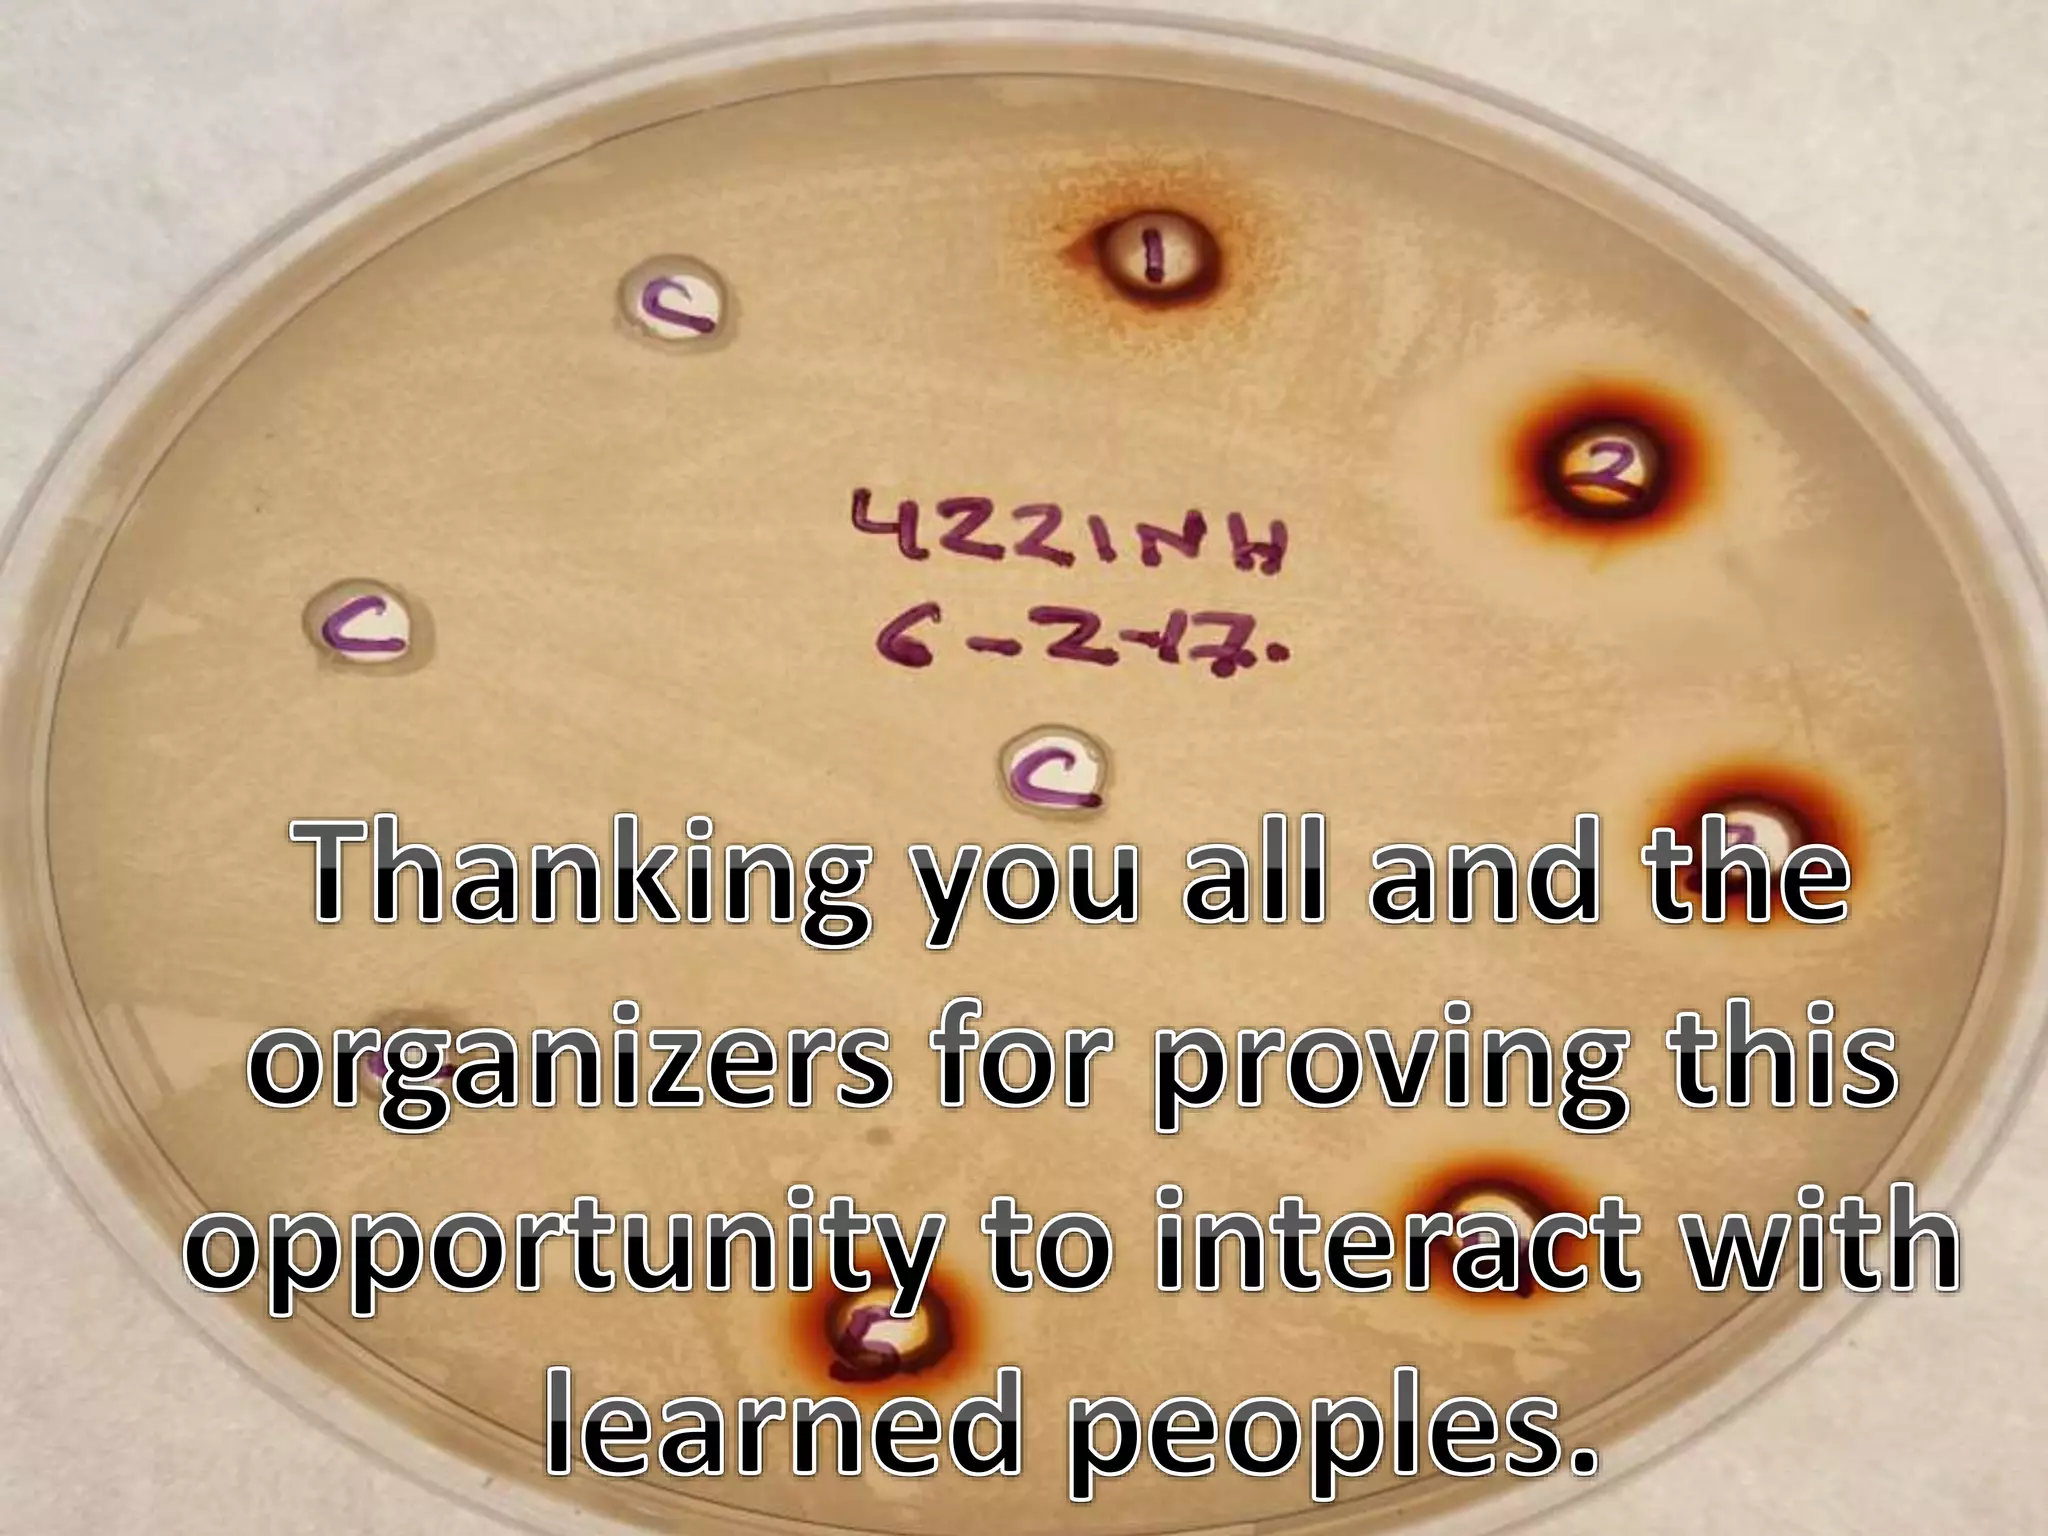
Antimicrobial drug resistance pattern of bacteria isolated from cases of abortion  and metritis

This document discusses the causes and patterns of abortion and metritis in dairy animals, highlighting that over 5% abortion rates necessitate investigation. It identifies both non-specific and specific infectious causes, including various bacterial and viral pathogens, and provides data on antimicrobial resistance patterns observed in affected animals. Additionally, the study underscores the efficacy of certain herbal antimicrobials that may rival conventional antibiotics, advocating for further research into their application in veterinary medicine.